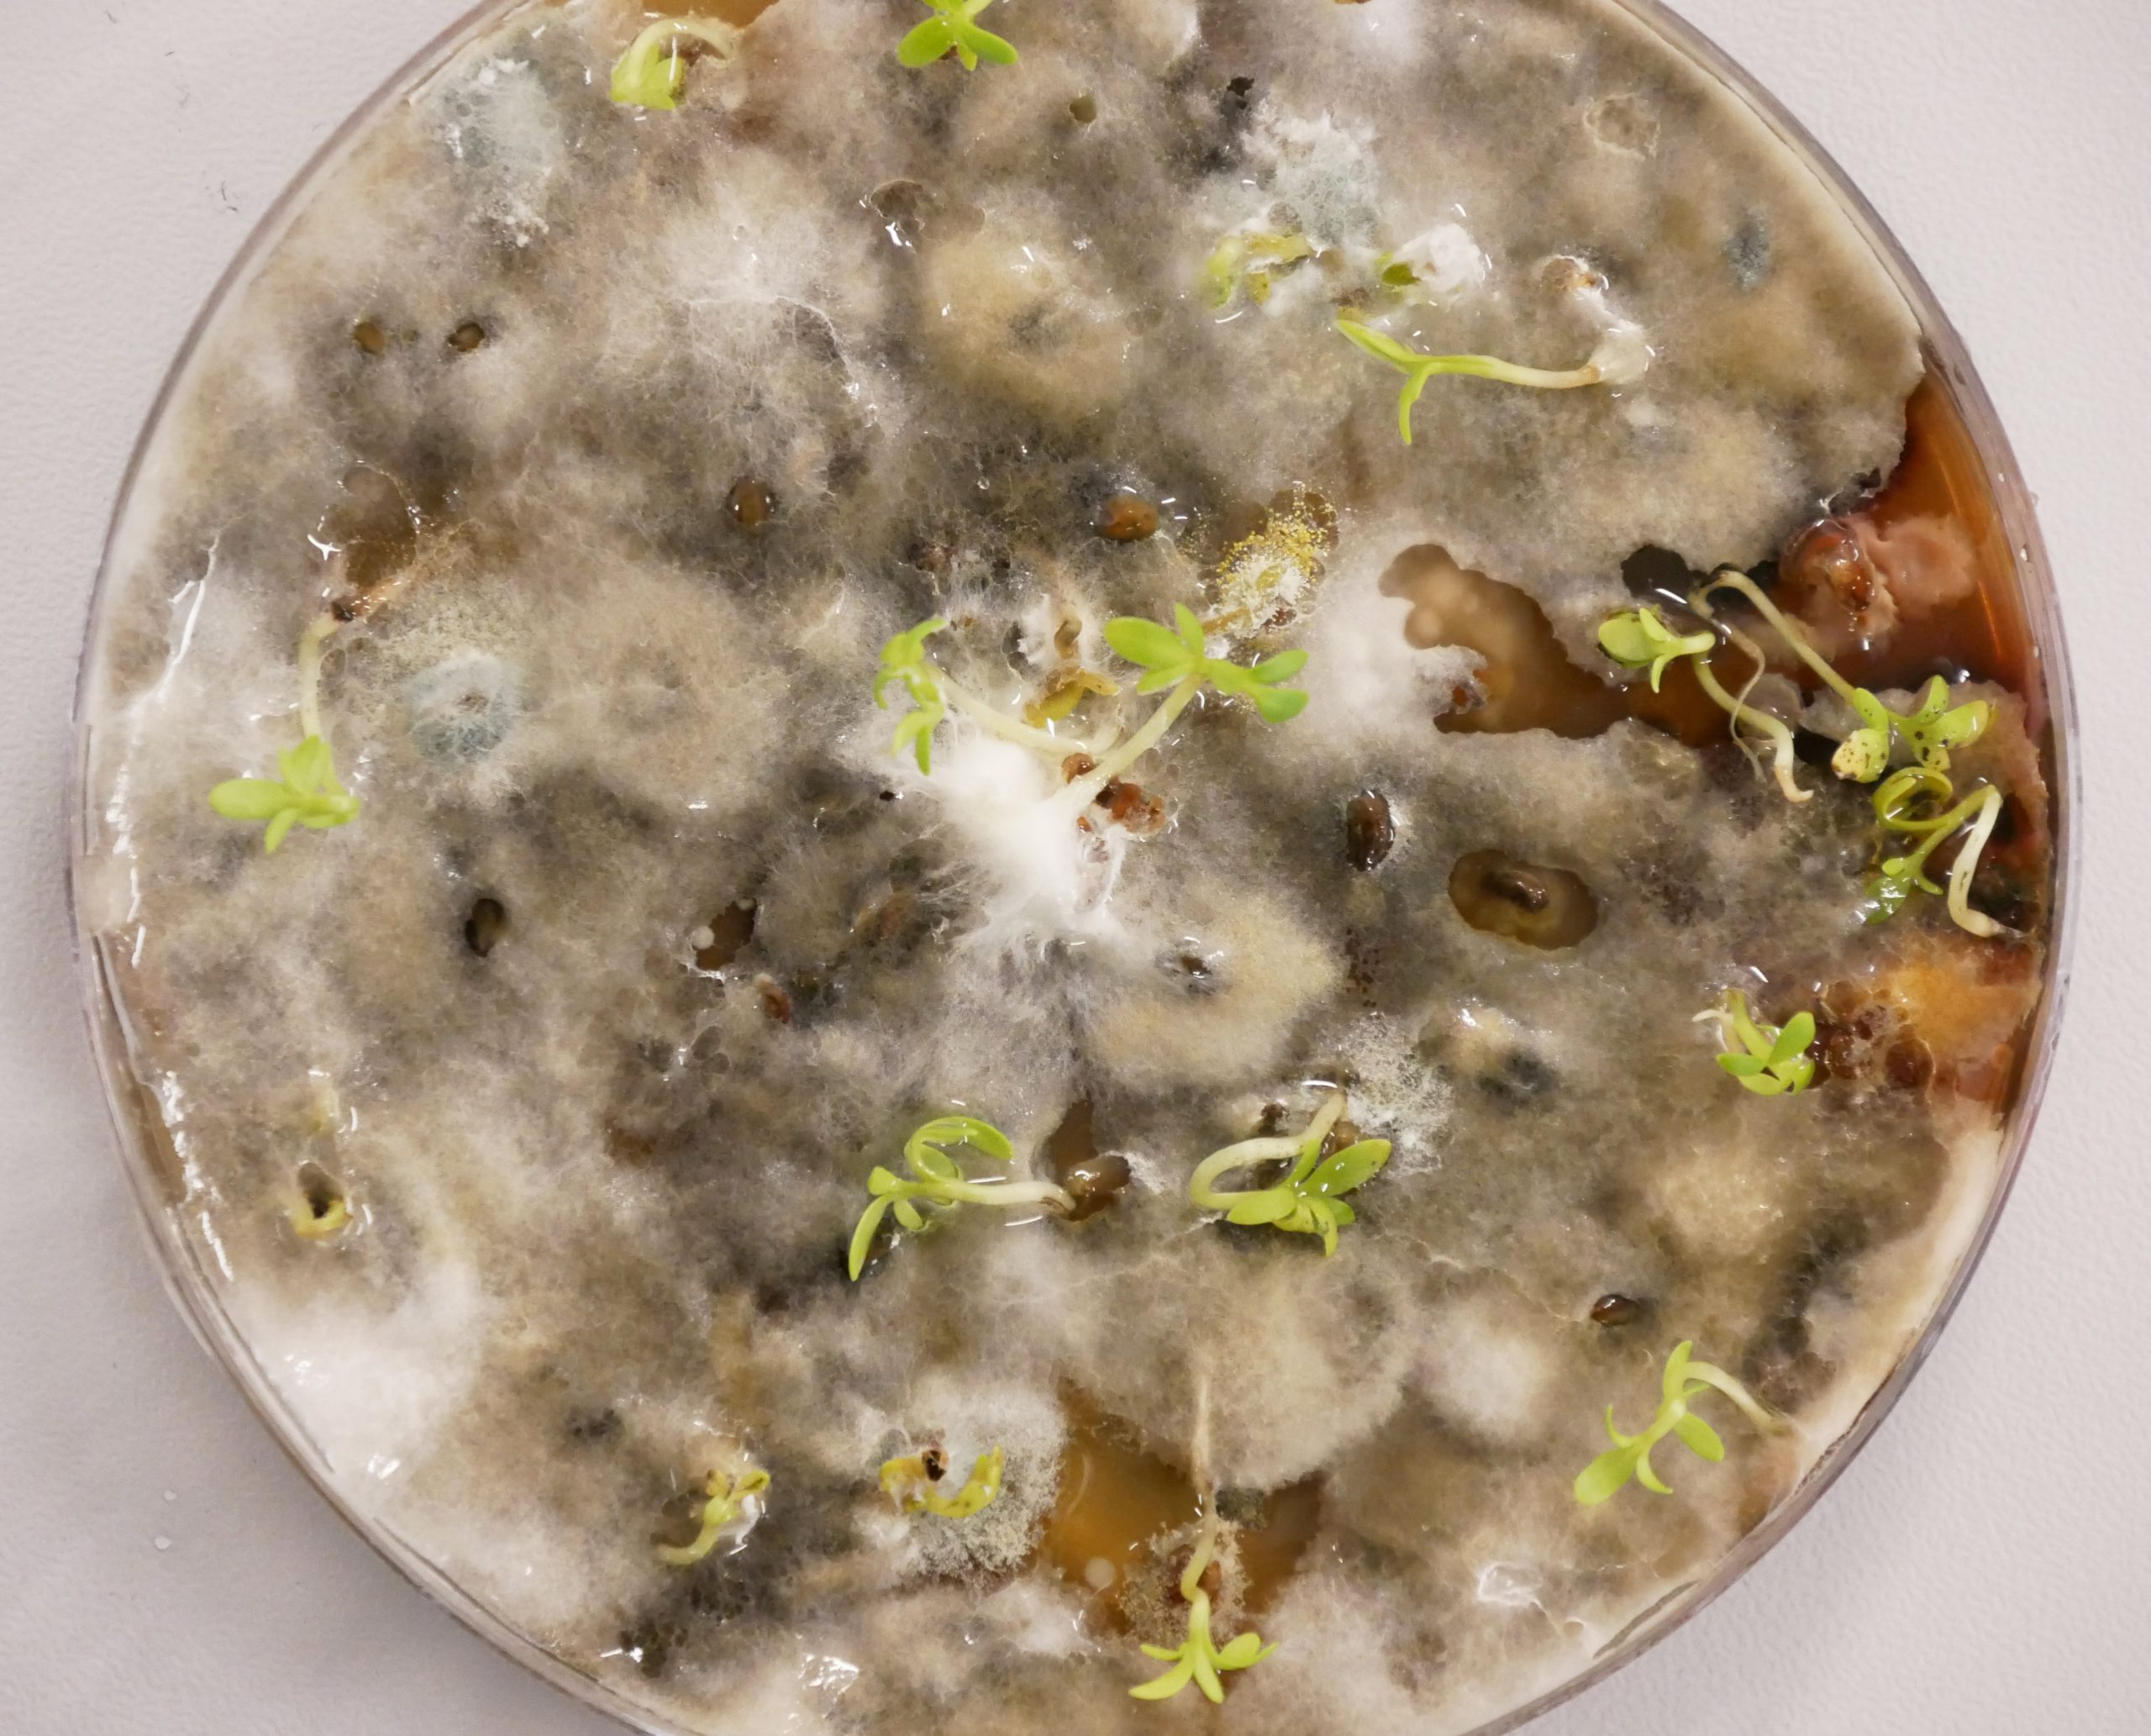

It is white, over two metres long and weighs about 25 kilos. A person can be buried in it, but the most important thing is: it lives. The Loop Living Cocoon is made of mycelium, the underground root network of mushrooms. After burial, this coffin innovation does not burden nature with hundreds of kilos of CO2, but literally adds life to it. “I do this for nature, that is my motivation. At the same time, I am proud that this beautiful, circular innovation now has a real business case,” explains entrepreneur Bob Hendrikx.
The world of Bob Hendrikx (27) has been turned upside down. His company Loop Biotech, located on the TU Delft Campus, seems to have gained momentum. His product – the world’s first living coffin – is attracting national and international attention. Bob has just heard that his company has won the ASN World Prize, an award for sustainable start-ups.
Better organisation
In the meantime, orders for the Loop Living Cocoon from funeral directors are starting to pour in. “It is time to take a closer look at the ordering procedure, including the follow-up, to make it an efficient flow. We are in that phase of ‘better organisation’. This is starting to look more and more like a business,” laughs Bob, who now develops, produces his cocoons and delivers to the undertakers with the help of five employees including trainees.
A living coffin, made of mycelium. “It is the world’s best recycler,” Hendrikx explains, “that converts dead organic material into valuable nutrients for new nature. In the ground, the mycelium decomposes within 45 days and is once again ‘one with nature’. If you let yourself be buried in this cocoon, you feed the earth with your own nutrients. In fact, with your death you provide a source for new life.”
Living architecture
What was the spark that started this enterprise? “During my architecture studies at TU Delft, I was doing material research on industrial design. I wanted to do something with nature, make living architecture with algae and sea crystals, for example. One day in the materials lab, I had forgotten to dry a piece of mycelium. The material had grown together alive. That was a eureka moment: if I keep this material alive, I thought, it will have very interesting, solid characteristics.” After numerous experiments and tests the hardened mycelium became the raw material for the cocoon. “In fact, the material is on ‘pause’ until burial. Under the ground, the material comes to life, with a human in it.”
“I am proud that this beautiful, circular innovation now has a real business case”
Bob Hendrikx
CEO & Founder
Current funeral processes have a negative co2 footprint. To be precise, cremation produces 250 kilos of co2 and regular burial 100 kilos. “To compensate for these emissions, ten and four trees respectively are needed. With our Loop Living Cocoon, you have a positive footprint. We are still calculating exactly how much, but you are doing something good for nature.” On top of that, a normal coffin containing a human being decomposes in twenty to thirty years. In the Cocoon, it takes two to three years.”
One with nature
The concept has raised a lot of interest among funeral businesses. “I notice that they understand the vision that we should try to become more one with nature after death. It is true: with the Loop Living Cocoon, you’re doing the earth a favour.” The young entrepreneur notes that his product fits in seamlessly with a current trend in society. “People want to live in harmony with nature. That is becoming more important to many than purely economic prosperity. Sustainability and circularity are high on the list of priorities for many people. The Loop Living Cocoon is a product with which everyone can make this intention a reality. We focus on life. Not on life with an end but on a cycle that repeats itself. That is why we prefer not to call our product a ‘coffin’ but rather the Loop Living Cocoon. Our product brings people back to nature after their death.”
Ideas for the future
The Loop Biotech company is also full of life and ideas for the future. “We are constantly developing and improving and want to build up a whole portfolio of funeral products. Eventually, we want to take the step towards composting the deceased – if that becomes legally possible in the long run,” says Bob Hendrikx, whose own ‘fuel’ comes from the TU Delft ecosystem. “We are pleased that Loop Biotech is located on the TU Delft Campus and particularly in YES!Delft, the gathering place for startups. After all, here we are close to the beating heart of TU Delft. This is also where we get our ideas, where we find our connections with other entrepreneurs and with graduates and interns. The connection with talent is tangible; here, there is a very fine ‘vibe’ of pioneering and development. We are the living – pun intended, haha – proof of that, with our innovation.”